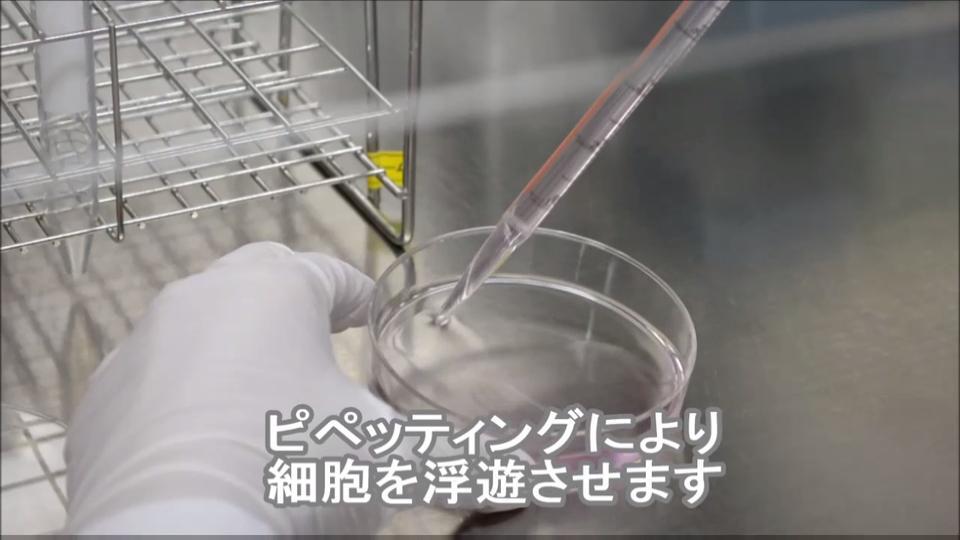

★ ヒト間葉系幹細胞の融解・培養・継代のプロトコールはこちら
凍結細胞の融解・培養プロトコール
細胞が到着後、すぐに液体窒素中に移して保存するか、またはすぐに培養を始めてください。
- 培地を準備する。
細胞の推奨播種密度(Plating Density;添付の英文説明書に記載)に従って、必要な培養面積を計算する。
適切なPromoCell社の専用増殖培地を培養フラスコ(またはディッシュ)に適量入れる。(細胞1 vialにつき、9 ml以上)
37℃、5% CO2インキュベーター内に30分静置する。

-
細胞を融解する。
細胞のバイアルを液体窒素から取出し、直ちにドライアイス上に置く。
バイアルの内圧を下げるためにクリーンベンチ(層流ベンチ)内で、バイアルの蓋を1/4回転ほど少し緩めて、再度締める。注意: 移動距離が短い場合も必ずドライアイスを使用し、バイアルをドライアイス上から直接37℃ウォーターバスに移してください。
バイアルをスクリューキャップのすぐ下の位置まで37℃ウォーターバスに2分間浸す。この時スクリューキャップの部分を水に浸さない様に注意する。
注意: 融解時間は2分を厳守し、融解中にバイアルをウォーターバスから出して観察することは避けてください。 融解中にバイアルを取り出すと、バイアル内の温度が不均一になり、融解時間が長くなって細胞に悪影響を及ぼします。 
- バイアルを殺菌し、細胞を播種する。
クリーンベンチ内で、バイアルを70%エタノールで殺菌する。余分のエタノールを完全に除く。
バイアルの蓋をあけて、バイアル内の細胞をステップ1で準備した培地が入ったフラスコ内に移す。
注意: 遠心によって凍結培地を除く必要はありません。融解時の遠心操作は細胞の生存率に悪影響を及ぼすため避けてください。 
- 細胞のインキュベーション
培養フラスコを37℃、5% CO2インキュベーター内に移し、細胞を接着させる。16~24時間後に培地を交換する。
様子をみながら2~4日毎に培地交換を行う。
細胞が70~90%コンフルエントに達したら、継代を行う。

動画でもご覧ください
凍結細胞の解凍
細胞の継代プロトコール
- 試薬を用意し、細胞を洗浄する。
DetachKit(製品コード C-41200/C-41210/C-41220)を少なくとも30分間室温に静置する。
培養フラスコから注意深く培地を吸引して除去する。
培養フラスコにHepes BSS Solution*を100 μl/cm2加え、15秒間穏やかにフラスコを振盪して細胞を洗浄する。
* DetachKitに含まれる。

- 細胞を剥離する。
培養フラスコからHepes BSS solutionを注意深く吸引して除去する。
培養フラスコにTrypsin/EDTA Solution*を100 μl/cm2加える。
* PromoCell DetachKitに含まれる。
細胞が剥がれ始めたら、フラスコの側面を軽く叩いて残っている細胞も剥す。注意: 細胞の剥離は、室温で行うことをお勧めします。
フラスコの蓋をしめ、顕微鏡で細胞を観察してください。

- トリプシンを中和し、回収する。
培養フラスコにTrypsin Neutralization Solution*を100 μl/cm2加え、穏やかに振盪する。
細胞懸濁液を注意深く吸引して、遠心チューブに移す。
220×gで3分間遠心する。
* PromoCell DetachKitに含まれる。

- 細胞のインキュベーション
上清を捨てて、適切なPromoCell社の専用増殖培地を 1 ml加える。
注意深くピペッティングして細胞を懸濁する。
あらかじめ37℃に温めたPromoCell社の専用増殖培地を入れた新しい培養フラスコに、推奨播種密度に従って細胞を播種する。
培養フラスコを37℃、5% CO2インキュベーター内に入れて培養する。

動画でもご覧ください
細胞の継代
凍結細胞の融解・培養プロトコール
【ヒト間葉系幹細胞(製品コード C-12974、C-12971、C-12977)の場合】
細胞が到着後、すぐに液体窒素中に移して保存するか、またはすぐに培養を始めてください。 注意:間葉系幹細胞増殖培地XF(製品コード C-28019)を使用する場合は、フィブロネクチンでコートした培養容器が必要となります。
a)間葉系幹細胞増殖培地2(製品コード C-28009)を使用する場合。
細胞の推奨播種密度(Plating Density:4,000 cells/cm2)に従って、必要な培養面積を計算する。細胞数は試験成績書(COA)に記載されている。
間葉系幹細胞増殖培地2を培養フラスコ(またはディッシュ)に適量入れる。(細胞1 vialにつき、9 ml以上)
37℃、5% CO2インキュベーター内に30分静置する。
b)間葉系幹細胞増殖培地XF(製品コード C-28019)を使用する場合。
細胞の推奨播種密度(Plating Density:4,000 cells/cm2)に従って、必要な培養面積を計算する。細胞数は試験成績書(COA)に記載されている。
培養容器をヒトフィブロネクチンまたは、ウシフィブロネクチンにて10 μg/cm2 の濃度でコートする。
間葉系幹細胞増殖培地 XFをフィブロネクチンコート済みの培養フラスコ(またはディッシュ)に適量入れる。(細胞1 vialにつき、9 ml以上)
37℃、5% CO2インキュベーター内に30分静置する。

細胞のバイアルを液体窒素から取出し、直ちにドライアイス上に置く。
注意:移動距離が短い場合も必ずドライアイスを使用し、バイアルをドライアイス上から直接37℃ウォーターバスに移してください。
バイアルの内圧を下げるためにクリーンベンチ(層流ベンチ)内で、バイアルの蓋を1/4回転ほど少し緩めて、再度締める。
バイアルをスクリューキャップのすぐ下の位置まで37℃ウォーターバスに2分間浸す。この時スクリューキャップの部分を水に浸さない様に注意する。
注意:融解時間は2分を厳守し、融解中にバイアルをウォーターバスから出して観察することは避けてください。融解中にバイアルを取り出すと、バイアル内の温度が不均一になり、融解時間が長くなって細胞に悪影響を及ぼします。

クリーンベンチ内で、バイアルを70%エタノールで殺菌する。余分のエタノールを完全に除く。
バイアルの蓋をあけて、バイアル内の細胞をステップ1で準備した培地が入ったフラスコ内に移す。
注意:遠心によって凍結培地を除く必要はありません。融解時の遠心操作は細胞の生存率に悪影響を及ぼすため避けてください。

培養フラスコを37℃、5% CO2インキュベーター内に移し、細胞を接着させる。
3~4時間後に培地を交換する。様子を見ながら2~3日毎に培地交換を行う。
細胞が70~90%コンフルエントに達したら、継代を行う。

細胞の継代プロトコール【ヒト間葉系幹細胞の場合】
注意:間葉系幹細胞増殖培地XF(製品コード C-28019)を使用する場合は、フィブロネクチンでコートした培養容器が必要となります。Accutase-Solution(製品コード C-41310)を少なくとも30分間室温に静置する。培養フラスコから注意深く培地を吸引して除去する。培養フラスコにHepes BSS Solution(製品コード C-40010)を100 μl/cm2 加え、15秒穏やかにフラスコを振盪して細胞を洗浄する。

培養フラスコからHepes BSS solutionを注意深く吸引して除去する。
培養フラスコにAccutase-Solutionを100 μl/cm2加え、2~4分室温にてインキュベートする。顕微鏡で観察し、細胞が剥がれ始めたら、フラスコの側面を軽く叩いて残っている細胞も剥がす。

注意深く細胞懸濁液を吸引し、遠心管に移す。3分間 220×gにてスピンダウンする。

上清を捨てて、間葉系幹細胞増殖培地(2またはXF)を1 ml加える。注意深くピペッティングして細胞を懸濁する。予め37℃に温めた間葉系幹細胞増殖培地(2またはXF)を入れた新しい培養フラスコに、推奨播種密度に従って細胞を播種する。
培養フラスコを37℃、5% CO2インキュベーター内に入れて培養し、2~3日毎に培地を交換する。

- 注意事項
- 本ページの製品はすべて研究用として販売しております。ヒト、動物への医療、臨床診断用には使用しないようご注意ください。また、食品、化粧品、家庭用品等として使用しないでください。
- タカラバイオの承認を得ずに製品の再販・譲渡、再販・譲渡のための改変、商用製品の製造に使用することは禁止されています。
- タカラバイオ製品に関連するライセンス・パテントについては、ライセンスマークをクリックして内容をご確認ください。
また、他メーカーの製品に関するライセンス・パテントについては、各メーカーのウェブサイトまたはメーカー発行のカタログ等でご確認ください。 - ウェブサイトに掲載している会社名および商品名などは、各社の商号、または登録済みもしくは未登録の商標であり、これらは各所有者に帰属します。